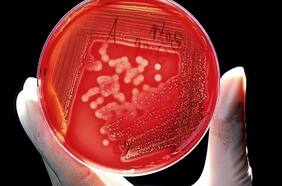
Detectan casos de gonorrea resistente en Reino Unido

Resistencia Antimicrobiana
26 MAYO
Un equipo de la Universidad de Chile realizó un hallazgo que advierte que ciertos microorganismos serían híper resistentes a los antibióticos, lo que permitiría a la comunidad científica adelantarse al surgimiento de posibles nuevos mecanismos que pueden traspasar su poder de resistencia a otros microorganismos y generar con ello un riesgo para la salud global.
Investigadores chilenos descubren bacterias con “súperpoderes” en la Antártida
Lo más leído
1.
3.
4.
5.